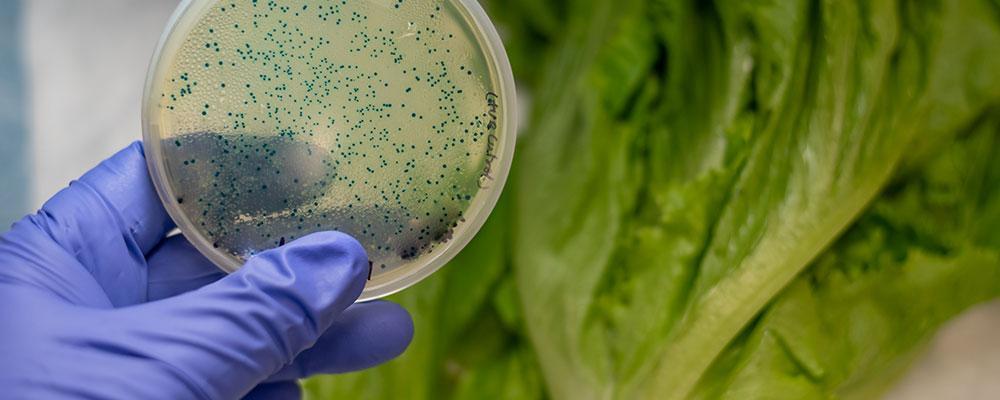
Chicago E. coli Poisoning Attorney

312-981-0409
33 N Dearborn St 10th Floor, Chicago, IL 60602
Serving Clients Across 8 Illinois Locations
Illinois E. coli Food Poisoning Attorneys
E. Coli Injury Lawyers Serving the Chicago Area
Escherichia coli – or E. coli – is one of the more common types of bacteria that causes food poisoning in the United States. The Centers for Disease Control and Prevention (CDC) estimates there are 265,000 E. coli-related illness cases across the country each year, resulting in 3,600 hospitalizations and 30 fatalities.
There are numerous types of E. coli, which are found in the intestines of animals and people, foods, and the environment. Many strains are not harmful and actually support a healthy human intestinal tract. Others can cause severe sickness.
If you were sickened by E. coli, Newland & Newland, LLP will fight for the compensation you need for a full recovery.
Past settlements for our clients include $53,000 for food poisoning that led to multiple days in the hospital.
Shiga Toxin E. coli
Some E. coli produce Shiga toxin, which attacks cells within the body similar to ricin, a highly potent poison. These bacteria are classified as Shiga toxin-producing E. coli, known by the abbreviation STEC. There are numerous variations, including E. coli 0157, which is often the type associated with large-scale outbreaks that make national headlines.
Causes of E. coli Bacterial Infection
Nearly 70 percent of E. coli bacteria is spread via food. The leading sources of E. coli include:
- Meat contaminated during processing from infected intestines, especially ground beef;
- Unpasteurized cheese, milk, and juices;
- Vegetables including spinach, lettuce, and sprouts; and
- Raw cookie dough.
Additional ways to contact E. coli include from petting animals at a petting zoo, and by eating foods prepared by people who did not wash their hands after using the toilet and other unclean or unsterilized environments.
E. coli Symptoms
Those sickened by E. coli often experience stomach pain, vomiting, bloody stools, and diarrhea. Some instances include fever, but typically less than 101 degrees. Other strains of E. coli produce urinary tract infections, respiratory illness, and even pneumonia.
As far as what to do if you get food poisoning, if these symptoms persist for more than three days, visit your family physician or your closest healthcare facility. Your doctor may prescribe an antibiotic and replenish your fluids via IV if you are significantly dehydrated.
While E. coli illness usually passes within five to seven days, around 5 to 10 percent of E. coli 0157 cases develop hemolytic uremic syndrome (HUS), which is a form of kidney failure. Symptoms may include infrequent urination, fatigue, and the loss of pink color in the cheeks and lower eyelids. Young children and the elderly are most susceptible to HUS.
How to Prevent E. coli Infection
Always wash your hands vigorously before you prepare food, especially when you have been in contact with animals or infants. Cook ground meats to an internal temperature of 160 degrees, or 145 degrees for beef roasts and steaks. Thoroughly clean all cutting boards and utensils after they come in contact with raw meat.
Also, do not open your mouth in swimming pools, ponds, or lakes, as swallowing even a small amount of contaminated water can cause E. coli infection.
Contact a Chicago E. coli Injury Lawyer
Food poisoning can cause severe discomfort, and in some cases, complete organ failure. Unfortunately, E. coli outbreaks in the United States are common, including at local eateries and national restaurant chains. If you became ill after eating contaminated food, negligence could be to blame, and you may be entitled to compensation for your medical costs and pain and suffering. To learn how the skilled Illinois personal injury lawyers at Newland & Newland, LLP can help get the financial award you deserve, contact us today at 312-981-0409 for a free phone consultation. We have five convenient locations throughout the Chicago area to serve you including Arlington Heights, Libertyville, Chicago, and Itasca.
-

Foreclosure and Bankruptcy
Visit Website -

Real Estate and Estate Planning
Visit Website -

Personal Injury
Visit Website

 Spanish
Spanish Cantonese
Cantonese















